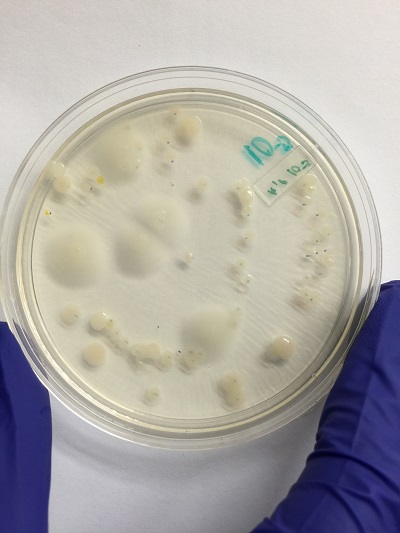
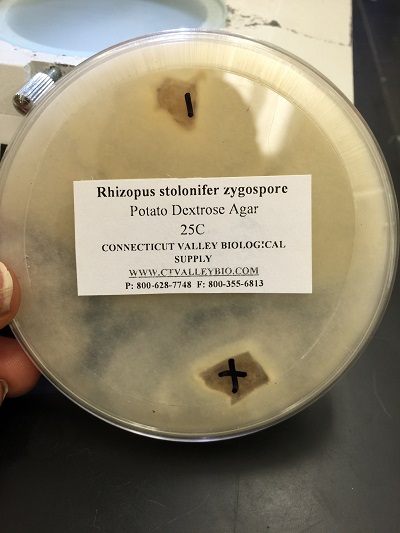

User:Portia P. Ofori/Notebook/Biology 210 at AU
2/25/16
Header: Effect of light rearing conditions on the embryonic development of zebra fish
Purpose: Observe the changes in developmental patterns in zebra fish reared in abnormal light conditions
Hypothesis and predictions: There will be a decrease in the overall size and the development of other body parts such as pectoral fin as well as body and tail pigmentation in those grown in constant light or constant darkness compared to the normal cyclic light reared ones. Our predictions were that there will be a decrease in the size of larvae in dark conditions due to the difficulty to find food a higher death rate with abnormal morphological growth in larvae reared in constant light due to the excessive exposure to light and heat.
Materials and method: Adult zebra fish were allowed to spawn and embryos collected at 24 hpf. The embryos were then placed in one of the three light conditions namely constant light (CL), Constant darkness (CD) and normal cyclic light (NCL). All were kept in Petri dishes with fresh water daily, fed with 15 micro liters of mixed paramecium culture starting from 4 days post fertilization (dpf) and observed for two weeks under controlled and experimental conditions at room temperature. Dissecting microscopes and depression slides were used to determine the developmental stages and larvae that were thought to be informative were anesthetized using 0.02% tricaine and then preserved with formaldehyde.
Conclusions and future directions: The Zebrafish reared under light were relatively small overall body size(0.4 mm)and tail length, had abnormal morphological features such as curved tails, undeveloped pectoral fins,reduced melanophores and had the highest death rate compared to the those reared in normal cyclic light. Surprisingly those reared in the dark conditions had the lowest death from day 11-14 but were slightly smaller in size (0.5 mm) than the control group (0.6 mm). By day four, 75%,38% and 29% of hatched embryos were observed in Normal cyclic, light and dark rearing conditions respectively. On day seven 54% of hatchings were alive and had some kind of sporadic movement while only 35%of hatching were alive in both light and dark reared Zebrafish. Percentage of hatchings alive in the control group on day eleven decreased to 29% and those in the light reared conditions dropped to 4%. Surprisingly none of the dark reared hatching died. All the zebrafish reared in constant light conditions or the control group died by day 14 however 13%of the dark reared zebrafish remained alive. One likely reason for the high death rate in the light conditions might be due to excessive heat from the light source. the decrease in body size in the dark reared zebrafish may be due to the limitation of finding food in the dark. other human errors such as failing to feed the fish daily, replacing each well with fresh water daily, using pipettes contaminated with other chemicals to fill wells could have contributed to the defective morphology and a poor developmental patterns. Future recommendations include close and frequent monitoring of zebrafish in the laboratory and checking the PH of the water habitat to ensure a favorable physiological PH for optimal growth.
Excel spreadsheets of development of embryo observed.
Dead and decomposing Zebrafish reared under constant light observed with a dissecting microscope.
Zebrafish reared under normal cyclic light
Zebrafish reared under constant darkness
PO
2/18/16
Header: Sequence analysis of 16S
Purpose: The purpose of this experiment was to identify the species of bacteria on the transect by amplification of 16S through the polymerase chain reaction technique (PCR)
CTCCTNNNACGNGTCACCGNCTTCAGGTACCCCATNNNNNCCATGGCTTGACGGGC GGTGTGTACAAGGCCCGGGAACGTATTCACCGCGCCATGGCTGATGCGCGATTACTAGCGATTCCAGCTTCATAGAGTCG AGTTGCAGACTCCAATCCGAACTGAGACCAGCTTTCGAGATTCGCATCCAGTCACCTGGTAGCTGCCCTCTGTACTGGCC ATTGTATTACGTGTGTGGCCCAAGGCGTAAGGGCCGTGATGATTTGACGTCATCCCCACCTTCCTCTCTACTTGCGTAGG CAGTCTCACTAGAGTCCCCAACTGAATGATGGCAACTAGTGACAGGGGTTGCGCTCGTTGCAGGACTTAACCTAACACCT CACGGCACGAGCTGACGACAACCATGCAGCACCTTGAAAAATGTCCGAAGAAAAGTCTATTTCTAAACCTGTCATTTCCC ATTTAAGCCTTGGTAAGGTTCCTCGCGTATCATCGAATTAAACCACATAATCCACCGCTTGTGCGGGCCCCCGTCAATTC CTTTGAGTTTCAGACTTGCGTCCGTACTCCCCAGGTGGCTAACTTATCACTTTCGCTTAGTCTCTGAATCCGAAAACCCA AAAACGAGTTAGCATCGTTTACGGCGTGGACTACCAGGGTATCTAATCCTGTTCGCTCCCCACGCTTTCGTCCATCAGCG TCAGTTGTTGCTTAGTAACCTGCCTTCGCAATTGGTGTTCTAAGTAATATCTATGCATTTCACCGCTACACTACTTATTC CAGCTACTTCAACAACACTCAAGACCTGCAGTATCAATGGCAGTTTCACAGTTAAGCTGTGAGATTTCACCACTGACTTA CAGATCCGCCTACGGACCCTTTAAACCCAATAAATCCGGATAACGCTTGCACCCTCCGTATTACCGCGGCTGCTGGCACG GAGTTAGCCGGTGCTTATTCGTATAGTACCTTCAGCTTNCCACACGTGGAAAGGTTNNTCCCTATACNAAAGAAGTTTAN NNCCATNNGNNNTCGNCTTCACGCGGGNTGNTGGNTCAGNTCTCANCCNTGNCNANNTCNTCANNGCTGCNTCCCGNAGN ANTCNGGNCC
Conclusion: It was identified that this 16S ribosomal RNA gene is a 99% match sequence to the bacteria Chryseobacterium sp. The sequence above was copied and pasted in NCBI BLAST and a graphical summary of the nucleotide sequence as well as the sequences producing significant alignment was generated. It is a gram-negative, non-motile filamentous rod bacteria of approximately 0.5 µm in diameter and 1.0 – 3.0 µm in length. The rods have rounded ends and parallel sides.
This sequence was borrowed from Ricardo Rodriguez and Lauren Wason.
PO
2/11/16
Header: Invertebrates and vertebrates (Analyzing the invertebrates collected with the Berlese funnel)
Purpose: Identify five vertebrates from the Berlese funnel collection using the dichotomous key.
Conclusion: The size range of organisms from the Berlese funnel ranged from 2mm to 4mm. the largest were the winged termites and the smallest were the Thrips. Organisms in the top and bottom portions of the Berlese funnel were similar.
| Organism( Phylum and Class) | Length in mm | Number in sample | Description of Organism | Organism |
| Arthropoda, Insecta | 3 | 1 | Body laterally compressed; legs modified for jumping | Flea |
| Arthropoda, Insecta | 4 | 2 | wings equal size, small social insects living in large colonies | winged Termite |
| Arthropoda, Insecta | 2 | 1 | have wings, long and narrow, fringed.minute insects with sucking mouth parts | thrips |
| Arthropoda, Insecta | 3 | 1 | soft bodied insect, with distinct constriction between thorax and abdomen | termite |
| Arthropoda, Insecta | 3 | 1 | Hard bodied insect with distinct cconstriction between thorax and abdomen. | Ant |
Header: Vertebrates and Niches.
Purpose: To identify, organize and classify vertebrates starting with phylum through species. To construct a food web based on all the groups of organism observed on transects. To describe the biotic and abiotic characteristics of transect that benefits each species.
Description of how organisms represent the ecological concept of community, carrying capacity and trophic levels: Live and dead leaves, dead animals, grass, acorn and rotten tree back serves as primary producers for squirrels, bacteria, archaea and crickets (primary consumers). The earthworm, Lizard and Millipede act as secondary consumers while the Robin and trush bird are tertiary consumers. The feeding strategy of the hawk is a Quaternary consumer.
Classification of organisms
| Vertebrate | Phylum | Class | Order | Family | Genus | Species |
| Squirell | Chordata | Mammalia | Rodentia | Sciuridae | Sciurus | Sciurus carolinensis |
| Robin | Chordata | Aves | Passeriformes | Turdidae | Turdus | Turdus migratorius |
| lizard | Chordata | Reptilia | Squamata | Agamidae | Agama | Agama agama |
| Trush bird | Chordata | Aves | Passeriformes | Turdidae | Turdus | Turdus philomelos |
| Hawk | Chordata | Aves | Falconiforms | Accipitridae | Accipiter | Accipiter cooperii |
Food Web based on all the organisms observed on transect 4.
Sample images of insect observed using a dissecting microscope.
PO
2/4/16
Header: Plantae and Fungi
Purpose: Describe the five plants and their location on the Transect, using the information to identify the major groups and genus for the samples.
| Transect sample plant | Location and # in the transect | Description (Sixe and shape) | Vasculirization | Specialized structures | Mechanism of reproduction |
| #1 Leaf | North of transect. Behind the wall | 3 cm | Dicot | Xylem and Phloem | Seeds |
| #2 Flower | East side of the transect | 1 cm | Dicot | Xylem and Phloem | Seeds |
| #3 Grass | Edges of the pond | 6 cm | Monocot | Photocynthetic cells | Seeds |
| #4 Dead leaf | Ground, east side of transect | 6 cm | Dicot | Xylem and Phloem | Seeds |
| #5 Dead fern-like leaf | West side of transect | 1 cm | Dicot | Xylem and Phloem | Seeds |
| #6 Acorn | By the side walks | 4 cm | Monocot | Spongy cotyledon | Seeds |
The only seed found on our Transect was an acorn which is a monocot. It is made up of a single seeded thick walled nut in a woody nut–like base, a cross section revealed a spongy cotyledon and a relatively hard pericarp.
Header: Plant Vascularization
Purpose: Characterize the vascularization in each of the plants from transect.
Three leaves observed were Dicots with net veins. The grass however was a monocot because it possessed parallel veins. The flowers had petals that were in multiple of four and so was classified as a Dicot. The seeds of both Monocots and dicots can be recognized by the arrangement of vascular tissue. This vascular tissue consist of Xylem, used for water transport and Phloem, which carries sugar and other nutrients from leaves to other parts of the plant.
The leaves and grass measured 1-6 centimeters in height as shown from table 1 above.
Preparation and observation of a cross section of leaves and seeds.
Materials needed: Microscope slide. Microscope, scalpel blade
Obtain a clean microscope slide and cut a tiny piece of the leaf or seed of interest. Add a drop of water from a pipette and observe under the microscope.
Header: Presence of specialized cells
Purpose: Describe the size, shape and arrangement of leaves from the transect plant.
Transect sample 1 was a leaf, 3 cm long, a dicot (leaf is net veined) and uses seeds as a mechanism of reproduction. The leaf is palmately lobed meaning the lobes spread radially from a point
Transect sample 2 was a flower with petals in multiple of four which categorizes it as a Dicot.
Transect sample 3 was grass, 6 cm long with simple cross sectional structures showing photosynthetic cells. It is a monocot with parallel veined leaf. The margins of the leaf was continuous long and thin.
Transect sample 4 was a dead leaf, also 6cm in length and possess xylem and phloem.
Transect sample 5 was a dead fern-like leaf, 1cm in length with a complex cross sectional cell structure. (Presence of xylem and phloem.)
Header: Mechanism of plant reproduction
Purpose: Identify whether seeds from transect are monocot or dicot with any evidence of flower or spores.
Some flowering plants were observed on the Transect which was determined to dicot due to the multiple arrangement of petals. The only seed found was an acorn (Oak nut) which is a monocot. Although there were no evidence of spores some plants had budding flowers.
Header: Observing Fungi.
Purpose: Examine samples with the dissection microscope and conclude if they are fungi and which group they belong to.
Fungi sporangia are spore producing fungi. This is where meiosis and spore production occurs. The spores undergo mitosis and divide to form multicellular haploid gametophyte. The sample is a fungi because it has a large mass of hyphae filaments (mycelium) growing on the surface of the potato dextrose agar plate. There were some black bean-like or globelike structures that was suggestive of sporangia. The fungi belongs to a group of multicellular mold called zygosporagia (Zygomycetes)
Picture of a growing fungi on an agar plate.

Picture of an acorn and its cross section


picture of transect sample plants


PCR results from hay infusion culture.


Conclusion: transect sample #1,#2,#4 and #5 are dicots due to their vascularization and the special structures they have and samples #3 and #6 are monocots.
1/28/16
Header: Identification and characterization of bacteria.
Purpose: Identify species of bacteria based on motility, gram stain, colony morphology and sequencing of 16s ribosomal subunit gene.
Taking one last look at my hay infusion, I observed that the level of water has reduced, its color changed to brownish and had a pungent smell. Hypothesis: The hay infusion will become cloudier and have a more pungent smell from week to week because bacteria in the hay infusion is going to decompose. Archaea that can grow in moderate or room temperatures might grow on the agar plates but the Archaea organisms that thrive in extremely high or low temperatures might not grow.
Table 1: 100 fold serial dilutions results
| Dilution | Agar type | # Colonies on plate | Conversion factor | Colonies/ml |
| 10-3 | nutrient | 1040.00 | x 103 | 1040000 |
| 10-5 | nutrient | 60 | x 105 | 6000000 |
| 10-7 | nutrient | 2 | x 107 | 20000000 |
| 10-9 | nutrient | 3 | x 109 | 3000000000 |
| 10-3 | Nutrient + Tetracycline | 121 | x 103 | 121000 |
| 10-5 | Nutrient + Tetracycline | 1 | x 105 | 100000 |
| 10-7 | Nutrient + Tetracycline | 1 | x 107 | 10000000 |
| 10-9 | Nutrient + Tetracycline | 0 | x 109 | 0 |
Header: Quantifying and observing Microorganisms
Purpose: Observe and quantify organism in serial dilution grown on nutrient agar and nutrient agar with tetracycline.
Generally, Nutrient Agar plates grew more colonies compared to nutrient agar with tetracycline. Addition of tetracycline makes the agar selective with the kind of bacteria that can grow on the agar. Certain organisms will be inhibited from growing. The bacteria that can grow in the presence of tetracycline indicates the organism’s resistance to the effect of antibiotic but those that could not grow are susceptible or sensitive to the antibiotic.
Conclusion: Tetracycline reduces the number of bacteria that grows on the agar plate. It is important to also note that growth rate decreased with increase serial dilution.
Header: Tetracycline’s mechanism of action.
Purpose: Determine the mechanism of action for tetracycline and the types of bacteria that are sensitive to it.
Tetracycline’s mechanism of action is through penetration of bacterial cells by passive diffusion and the inhibition of bacterial growth by interference with protein synthesis or by membrane destruction (Schnappinger and Hillen). As indicated by Chopra and Roberts, tetracycline inhibit protein synthesis by preventing the attachment of aminoacyl-tRNA to the ribosomal acceptor (A) site. Tetracycline is used as a broad spectrum antibiotic for a wide variety of gram positive and gram negative bacteria. Organisms such as mycoplasmas, chlamydia, rickettsia and protozoan parasites are sensitive to it.
Works cited.
Schnappinger D, Hillen W. June 1996. Tetracyclines: antibiotic action, uptake, and resistance mechanisms. Archives of Microbiology, Volume 165, Issue 6, pp 359-369.
Chopra I and Roberts M. June 2001. Tetracycline Antibiotics: Mode of Action, Applications, Molecular Biology, and Epidemiology of Bacterial Resistance. The American society for microbiology. Microbiology and molecular biology reviews. Volume 65, Issue 2, pp 232-260.
Header: Bacteria characterization
Purpose: prepare a wet mount, stain and observe under a microscope to characterize the bacteria according to color, shape texture and gram stain reaction.
Materials: loop, microscope slide, coverslip, Kim wipe, staining tray.
Reagents needed: crystal violet stain, grams iodine, 95% alcohol, safranin stain, water.
Wet mount Procedure:
Sterilize a loop over a flame until it is bright red and let it cool before scrapping a tiny portion of growth from the surface of the agar.
Mix with a drop of water and cover with a cover slip.
Observe the wet mount using 10X and then 40X objective lens.
Gram stain procedure: Sterilize a loop over a flame and make a wet mount without covering with a cover slip.
Label the slide and heat fix after it has air dried.
Place the prepared slides on the staining tray and cover the smear with crystal violet for 1 minute and rinse with water
Cover the smear with grams iodine mordant for 1 minute and rinse with water.
Flood the smear with 95% alcohol for 10-20 seconds to decolorize and rinse gently with water.
Counter stain the smear with safranin stain for 20-30 seconds and rinse with water.
Blot excess water with Kim wipes, air dry and observe under the microscope.
Table 2: Characterization of Bacteria.
| Colony Label | Plate atype | Colony Description | Cell Description | Gram + or Gram - |
| 10-3 | Nutrient | 0.1-0.3 (cm)in diameter,cream in color | cocci and rods | gram - |
| 10-3 | Nutrient + Tetracycline | 0.5-1.2(cm)in diameter,yellow,raised and glistening surface | cocci | gram + |
| 10-5 | Nutrient | 1(cm), pale yellow and round colonies | Rod shaped | gram - |
| 10-5 | Nutrient + Tetracycline | 0.6(cm) pale yeloow and smooth surface | Rods and coocci | gram - |
Organisms observed after Gram stain.
nutrient agar 10^-3



nutrient agar plus tetracycline 10^-5

Pictures of colony growth of bacteria.
Nutrient agar 10^-3

Nutrient agar plus tetracycline 10^-5

1/21/16
Header: Hay Infusion culture observations.
Purpose: To observe the invisible world of unicellular eukaryotic organisms under a microscope and use the dichotomous key to identify protest and algae.
Hypothesis: Organisms in the various niches of the hay infusion will exhibit slight differences between them.
Materials: Microscope slides, cover slips, microscope, plastic pipette.
Method:
-Obtain three clean microscope slide and put a drop of the specimen from each niche.
-Cover with a cover slip and observe with a microscope at 4X and 10X.
-Use the 40X for resolution. Record the sizes using ocular micrometer
-Obtain a dichotomous key and use it to determine organism present.
Observations: The hay infusion culture appeared cloudy with a pungent smell. The hay infusion had changed color to light brown with three distinct layers. Molds were present on top of the liquid. There were no green shoots present. Fine granular-like sediments were seen at the bottom layer.
Organisms differ close to verses away from plant matter because they have different carrying capacities (the maximum number of individuals of species that can survive in a particular niche)
Using the dichotomous key to identify 3 different organisms from three niches in the hay infusion.
Top niche:
Paranema: Cell elongated, colorless with a broad or truncate posterior during locomotion. Highly plastic when stationary, often appears to vibrate when in motion. Amoeba: Small, creeps using pseudopodia and has a single disc shaped nucleus. Actinosphaerium: Colorless organism sliding slowing without apparent motion, spherical shaped with radiating spines.
Middle niche:
Colpidium: Small body, oval shaped and covered in cilia. Fast swimmer. Paranema: Cell elongated, colorless with a broad or truncate posterior during locomotion. Highly plastic when stationary, often appears to vibrate when in motion. Pelomyxa: large, creeps using pseudopodia, many (100s) of small nuclei.
Bottom niche:
Chilomonas (algae genus): Colorless, cells organ of locomotion is a long whip-like flagella (no cilia), single motile cell, 2 observed locomotor flagella at one end, cell elongated with narrowed posterior. The cell measures 20 ocular spaces using 40X objective lens. Paranema (protozoa): Cell elongated, colorless with a broad or truncate posterior during locomotion. Highly plastic when stationary, often appears to vibrate when in motion. Chlamydomonas (Algae): Cell is greenish, a single motile cell, two observed locomotor with an oval shaped body. The green color suggest photosynthetic activity.it measures around 10μm.
Description of how Chlamydomonas meets all the needs of life as described on page 2 of the freeman text.
Chlamydomonas has photosynthetic activity therefore absorbs sunlight as its source of energy. It has a cell membrane that regulates the passage of materials in and out of the cell. Chlamydomonas has a flagella which aids in movement. It can undergo both sexual and asexual reproduction.
If the hay infusion grew for another two months my prediction will be a reduction in the number of organisms present. Struggle for resources through which organisms survive and pass on genes to the next generation will be very evident. One selective pressure that will affect the community of my sample will be limitation of nutritional resources leading to competition for food and energy among microorganisms. Therefore if certain organisms have a lower chance of survival, they cannot stay alive to reproduce.
Diagrams of organisms observed in the different niches.
Header: Serial Dilutions.
Purpose: To prepare and plate serial dilutions of organisms in the hay infusion nutrient agar and enriched agar.
Materials: Four test tubes containing 10ml of sterile broth, micropipette set at 100μl, micropipette tips, four nutrient agar petri dishes, four nutrient agar with tetracycline petri dishes, test tube rack, inoculation spreader, Bunsen burner.
Method:
-Swirl hay infusion to mix up organisms.
-Aliquot 100μl of sample from hay infusion and add to 10ml of sterile broth (10-2 dilution)
-Swirl inoculated tube to mix and add 100μl from 10-2 dilution to 10-4 tube.
-Repeat above step to make the 10-6 and 10-8 serial dilutions.
-Pipette 100μl and inoculate on both nutrient and nutrient agar with tetracycline for each of the serial dilutions
-Place agar plate in a rack with the agar side facing up.
-Incubate at room temperature for one week.
Diagram of serial dilution procedure
1/14/16 Observation of a 20/20 transect
Location: The transect is located in an area behind the AU library close to the student health center. It is a 20 by 20 foot dimension marked with four Popsicle sticks with a pond at the center.
Topography: The transect had Cornus florida commonly called flowering dogwood, Parrotia persica treesome trees and some budding flowers as well. The soil was moist and covered mostly with fallen leaves. The sides of the pond was riprapped with rocks to protect it from wind, wave action and erosion. There were grass grown around the pond probably to prevent erosion.
Biotic Components: 1. Pond 2. Two big trees without leaves 3. Three short trees with green leaves and budding flowers 4. Mushrooms 5. insects
Abiotic component of transect:
1. Bamboo grid used to cover the pond
2. Net used to cover the pond.
3. Classroom block.
4. Lights form the classroom wall
5. Two lovers seats
6. Two statues ( Duck statue in the pond and a woman with three birds at her feet on land)
7. Irrigation control valve just above the pond.
8. Deflated balloon on land
9. Paper on land
10. Wiring that goes into the pond
11. Large and small rocks outlining the pond
| Characteristics | Chlamydomonas | Gonium | Volvox |
| Number of cells | 1 | 4 | 1(containing many smaller cells) |
| Colony size | 4os / 10μm | 8os /22μm | 22os / 220μm |
| Specialization of cells | Unicellular, egg-shaped, cup-shaped chloroplast | Gelatinous matrix | Multicellular, presence of spiked cells |
| Mechanism of motility | Flagella | Flagella | Flagella |
| Isogamous or Oogamous | Isogamous | Isogamous | Oogamous |
Pictures from the transect.
Aerial diagram of the transect